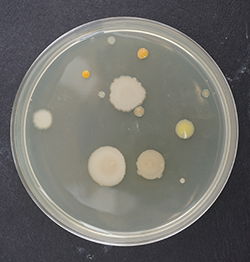

Ehető-e a hó? Viccesnek tűnő, de komoly kutatás a Sapientián

A csíkszeredai mikrobiológusok ismét érdekes kutatással jelentkeztek.
A Sapientia Erdélyi Magyar Tudományegyetem csíkszeredai karának mikrobiológusai korábban már jelentkeztek figyelemre méltó kutatási eredményekkel, például új baktériumfajokat fedeztek fel a szovátai Medve-tóban és a cekendi hulladéktározó csurgalékvizében. (Erről itt és itt olvashat).
Most egy első látásra banálisnak tűnő, de igazából rendkívül érdekes kérdést vizsgáltak: ehető-e a hó? Ehető, persze, de
mennyire egészséges a hóevés mikrobiológiai szempontból?
A kutatás tulajdonképen hiánypótló, mivel nem csak a gyerekek, hanem a felnőttek is gyakran megkóstolják a havat, miért ne tudnánk hát, mi kerül be a szervezetünkbe a hóevéssel?
A vizsgálatokat két alkalommal, 2017 januárjában és februárjában végezték, amelyek során Csíkszereda központi parkjában, illetve a Hargita Megyei Törvényszék melletti körforgalomnál vettek steril eszközökkel, tiszta helyről hómintákat, közvetlenül havazáskor, illetve utána kétnaponta, a hatodik napig.
A hómintákat laboratóriumban szobahőmérsékleten megolvasztották, majd táptalajok
segítségével kitenyésztették a mikrobákat, és meghatározták, hogy az egyes minták esetében mennyi a baktériumok és a penészgombák csíraszáma 1 milliliter hólében. A februári vizsgálat elején azt is megállapították, hogy 6,15 liter hó elolvadásából egy liter hólé keletkezik, azaz egy marék hó elfogyasztásával néhány milliliter hólé kerül be a szervezetbe.
A vizsgálatok eredményei alapján megállapítható, hogy mindkét mintavételi periódusban a baktériumok csíraszáma a frissen hullott hó esetében a legalacsonyabb (januárban 5 baktérium, míg februárban 20 baktérium milliliterenként), és a napok teltével a számuk nő.
Két nap múlva az átlagos csíraszám 65 baktérium, négy nap múlva pedig 103
baktérium/milliliter hólé. A 6. napi mintavétel során januárban maximálisan 180 baktérium, míg februárban 278 baktérium volt kimutatható milliliterenként a hóléből. A körforgalomnál vett hóminták esetében csak kissé voltak magasabb a baktériumok csíraszámai a parkéhoz viszonyítva.
A baktériumoktól eltérően a frissen hullott hóban nem mutattak ki penészgombát,
utána pedig a csíraszámuk 5-20 között volt milliliterenként, de az idő múlásával számuk nem mutatott nagy változást, nagyobbrészt stagnált, amely valószínűleg a penészgombák nagy hidegben történő kisebb túlélési arányával magyarázható. A hóléből kitenyésztett baktériumok egy jó része spórás volt (gyakran figyeltek meg jellegzetes fehéres, Bacillus baktérium nemzetséghez tartozó telepeket a táptalajokon), amelyek jobban túlélik a szélsőséges körülményeket.
A csíkszeredai vizsgálat összegzéseként elmondható, hogy városi környezetben kis számban ugyan, de még a frissen hullott hóban is előfordulnak élő mikrobák (főként baktériumok), amelyek elsősorban a levegőben lévő lebegő részecskék felszínéhez tapadnak, és ülepednek ki a lehulló hópelyhek révén.
Az idő múlásával nő a hó felületén kimutatható mikrobák (baktériumok és penészgombák) száma és diverzitása. Ez nem meglepő, hiszen a korábban elvégzett levegőmikrobiológiai vizsgálatokból is kiderül, hogy a városi levegő sem steril, még januárban is Csíkszeredában átlagban 105 baktérium és 48 penészgomba mutatható ki egy köbméter levegőből.
„Játszótéren tapasztaltakból kiindulva a vizsgálat tervezésekor – apaként és mikrobiológusként – az volt a fő kérdésem, hogy a gyerekek nyugodtan megehetik-e a havat? A mikrobiológiai vizsgálatok alapján a kérdésre a válaszom az, hogy nem tiltanám meg, hogy a gyerekek megkóstolják a havat, de ezt csak frissen hullott, vagy fél napnál nem régebbi hó esetében támogatnám”
– vonja le a következtetést dr. Máthé István.
A korábban említett Parisa Ariya a legújabb, 2016-os légkörkémiai vizsgálataik alapján ennél szigorúbban fogalmaz: nem javasolja, hogy városi környezetben a gyerekek havat egyenek! Laboratóriumi hókamrában végzett kutatásaik során bebizonyították ugyanis, hogy már néhány óra elteltével is jelentősebb mennyiségben mutathatók ki a hóból az autók kipufogó gázaiból származó, egészségre káros szennyező anyagok, például: benzol, toluol, xilol, amelyeket a hó magába szív – teszi hozzá a csíkszeredai mikrobiológus.
Generációk ellopott ifjúsága, avagy egy John Lydon nevű öreg punk a színpadon
Szántai János
Az öreg punk elővarázsolt egy fiatalembert, aki dühösen kérdőre vonta a közönséget. És nem tudtuk elmondani, hova lett a repülőgép, az Északi-sark, a büszke és szabad Magyarország és a többi…
Demeter András kicsinálása – szempontok egy igen gyorsan levezényelt, virtuóz akcióhoz
Fall Sándor
Azt nem tudni, hogy a lemondott miniszter ellen kik tervelték ki és hajtották végre az akciót, elképzelhető, hogy ez soha nem is fog kiderülni.
Az egyesült Nagy-Románia máig nem jelent egységesítést
Sólyom István
A mítosztalanított román–magyar közös történelem nem széles körű fogyasztásra alkalmas termék, de az MCC-történészkerekasztal előadói egyelőre optimisták.
„De hát én erdélyi vagyok, na” – a 90 éves Bodor Ádámot köszöntötték Kolozsváron
Varga László Edgár
Az író többek között arról beszélt, hogy ő „csak betévedt” az irodalomba, és arról is, milyen ambivalens érzésekkel tölti el a szülővárosába való visszatérés.

A romániai kommunizmus egyáltalán nem jelentette az itt élő népek testvériségét
Az 1989 előtti etnikai egyenlőség matematikája alapján tizenegy magyar diák nem tett ki hét embert. Utolsó előtti felvonásához érkezett az MCC-történészkerekasztal.

Még egy hónap, és újabb autópálya-szakaszon autózhatunk Erdélyben
Még a nyáron átadhatják az észak-erdélyi autópálya Magyarzsombor és Vaskapu közötti, 12 kilométeres szakaszát Szilágy megyében – közölte a közlekedési tárca illetékese.

Nicușor Dant Brüsszelből nem érdekli, hogy az AUR szavazataival állhat fel az új kormány…
… egy PNL-s főembert elvitt a DNA, az USR elnökére lesújtott Justitia kardja, az RMDSZ-re a botránytévék hányják a gyűlöletet… és tíz román állampolgár egymillió eurónyi drótot lopott Németországban.

Villámáradásokkal járt a heves zápor Udvarhelyszéken
Heves zápor csapott le kedden Székelyudvarhelyre és az udvarhelyszéki településekre. A rövid ideig tartó, de rendkívül intenzív esőzés miatt több utcán megállt a víz, pincéket öntött el a csapadék, a falvakban pedig kisebb áradásokat okozott.
Már az első napon összeomlott a rendszer: káoszba fulladt a képességfelmérő digitalizációja
A képességfelmérő vizsga első napját technikai hibák árnyékolták be: a dolgozatfeltöltő platform többször összeomlott, tanárok ezrei rekedtek órákra az iskolákban. A szakszervezetek szerint a minisztérium alkalmatlansága okozta a káoszt.

Nicușor Dan lehet Románia történetének első leváltott államfője – véli az USR volt elnöke
A Mentsétek meg Romániát Szövetség (USR) volt elnöke, Elena Lasconi szombaton felszólította Nicușor Dan államfőt, hogy vállalja a felelősséget a döntéseiért, és ismerje el a romániaiak előtt, hogy hibázott.

Továbbra sem tudni, milyen kormány lesz, ha lesz egyáltalán – hírek kedden
Az államfő ismét a parlamenti pártokkal konzultált a politikai válság meghaladásáról. Közben Szatmáron illegális kriptobányász-farmra bukkant az adóhatóság. A Transzfogarason medvéket etető turistákat pedig keményen büntetik.

Továbbra sem tudni, milyen kormány lesz, ha lesz egyáltalán – hírek kedden
Az államfő ismét a parlamenti pártokkal konzultált a politikai válság meghaladásáról. Közben Szatmáron illegális kriptobányász-farmra bukkant az adóhatóság. A Transzfogarason medvéket etető turistákat pedig keményen büntetik.

Nem szavazza meg az AUR a Veștea-kormányt, de várják a kijelölt miniszterelnököt megbeszélésre – hírmix
A külügyminisztérium egyik volt tisztviselője tizenöt évig utalt magának illegálisan fizetést. Továbbá: rendkívül kiterjedt illegális gyógyszerkereskedő hálózat működéséről rántották le a leplet Kolozsváron.

Nem szavazza meg az AUR a Veștea-kormányt, de várják a kijelölt miniszterelnököt megbeszélésre – hírmix
A külügyminisztérium egyik volt tisztviselője tizenöt évig utalt magának illegálisan fizetést. Továbbá: rendkívül kiterjedt illegális gyógyszerkereskedő hálózat működéséről rántották le a leplet Kolozsváron.

Ilie Bolojan lett újból a PNL elnöke. Jövőtől öt évre lezárják a Karánsebes–Szörényvár vasútvonalat felújítás miatt – hírek
Ludovic Orban pedig visszatérne a PNL-be.

Ilie Bolojan lett újból a PNL elnöke. Jövőtől öt évre lezárják a Karánsebes–Szörényvár vasútvonalat felújítás miatt – hírek
Ludovic Orban pedig visszatérne a PNL-be.

Mégsem indul a PNL elnöki tisztségéért vasárnap Adrian Veștea – hírek szombaton
További híreink: hatvannyolcszoros, jobban mondva százharminchatszoros kutyafülcsonkításért állhat bíróság elé egy férfi, keddig pedig csak a záporok, szélviharok szakítják meg a kánikulát.

Mégsem indul a PNL elnöki tisztségéért vasárnap Adrian Veștea – hírek szombaton
További híreink: hatvannyolcszoros, jobban mondva százharminchatszoros kutyafülcsonkításért állhat bíróság elé egy férfi, keddig pedig csak a záporok, szélviharok szakítják meg a kánikulát.

Nicușor Dant Brüsszelből nem érdekli, hogy az AUR szavazataival állhat fel az új kormány…
… egy PNL-s főembert elvitt a DNA, az USR elnökére lesújtott Justitia kardja, az RMDSZ-re a botránytévék hányják a gyűlöletet… és tíz román állampolgár egymillió eurónyi drótot lopott Németországban.

Nicușor Dant Brüsszelből nem érdekli, hogy az AUR szavazataival állhat fel az új kormány…
… egy PNL-s főembert elvitt a DNA, az USR elnökére lesújtott Justitia kardja, az RMDSZ-re a botránytévék hányják a gyűlöletet… és tíz román állampolgár egymillió eurónyi drótot lopott Németországban.

Akkora a kupi kormányalakítás körül, hogy ember legyen a talpán, aki átlátja – hírek csütörtökön
Közben Románia Szlovákiával közösen kéri, hogy az Európai Bizottság lazítson a medvéket védő szabályozásokon. Nyárádszeredában pedig tranzitdíjat vezettek be a kamionokra, a lépés az ott épülő autópályát is érinti.

Akkora a kupi kormányalakítás körül, hogy ember legyen a talpán, aki átlátja – hírek csütörtökön
Közben Románia Szlovákiával közösen kéri, hogy az Európai Bizottság lazítson a medvéket védő szabályozásokon. Nyárádszeredában pedig tranzitdíjat vezettek be a kamionokra, a lépés az ott épülő autópályát is érinti.

Kiengedték a börtönből Horațiu Potrát, Călin Georgescu zsoldosvezérét – hírmix
További híreink: a jelek szerint Adrian Veștea kormányalakítási kísérlete is halva született, de legalább egyre nagyobb a káosz, ha pedig súlyos inflációról van szó, Románia mindenkit toronymagasan megelőz.

Kiengedték a börtönből Horațiu Potrát, Călin Georgescu zsoldosvezérét – hírmix
További híreink: a jelek szerint Adrian Veștea kormányalakítási kísérlete is halva született, de legalább egyre nagyobb a káosz, ha pedig súlyos inflációról van szó, Románia mindenkit toronymagasan megelőz.

Nem támogatja az RMDSZ Veșteát, két új forgatókönyv is körvonalazódik kormányalakításra – hírmix
Szennyezett kavicsot használtak fel útjavításra egy Bihar megyei faluban, feljelentették a polgármestert. A romániai textilipar súlyos megrendelési visszaesésekkel küzd egy EU-s szabályozást követően.

Nem támogatja az RMDSZ Veșteát, két új forgatókönyv is körvonalazódik kormányalakításra – hírmix
Szennyezett kavicsot használtak fel útjavításra egy Bihar megyei faluban, feljelentették a polgármestert. A romániai textilipar súlyos megrendelési visszaesésekkel küzd egy EU-s szabályozást követően.

Száz nyestbőrrel a batyujában akart beutazni Romániába egy ukrán állampolgár – hírmix
Több mint félmilliárd lej eltitkolt vagyonra derített fényt az ANAF legújabb ellenőrzése. Népszavazással váltottak le egy Maros megyei polgármestert.

Száz nyestbőrrel a batyujában akart beutazni Romániába egy ukrán állampolgár – hírmix
Több mint félmilliárd lej eltitkolt vagyonra derített fényt az ANAF legújabb ellenőrzése. Népszavazással váltottak le egy Maros megyei polgármestert.

Adrian Veștea PNL-s politikust kérte fel az államfő kormányalakításra, a párt megkérdezése nélkül – hírek
Előbb esőzések és szélviharok, aztán kánikula jön országszerte. Továbbá sikerült kompromisszumot kötni a lengyel gyártóval: a pályaudvaron rekedt új vonatokat napokon belül üzembe helyezik.

Adrian Veștea PNL-s politikust kérte fel az államfő kormányalakításra, a párt megkérdezése nélkül – hírek
Előbb esőzések és szélviharok, aztán kánikula jön országszerte. Továbbá sikerült kompromisszumot kötni a lengyel gyártóval: a pályaudvaron rekedt új vonatokat napokon belül üzembe helyezik.
Generációk ellopott ifjúsága, avagy egy John Lydon nevű öreg punk a színpadon
Szántai János
Az öreg punk elővarázsolt egy fiatalembert, aki dühösen kérdőre vonta a közönséget. És nem tudtuk elmondani, hova lett a repülőgép, az Északi-sark, a büszke és szabad Magyarország és a többi…
Demeter András kicsinálása – szempontok egy igen gyorsan levezényelt, virtuóz akcióhoz
Fall Sándor
Azt nem tudni, hogy a lemondott miniszter ellen kik tervelték ki és hajtották végre az akciót, elképzelhető, hogy ez soha nem is fog kiderülni.
Az egyesült Nagy-Románia máig nem jelent egységesítést
Sólyom István
A mítosztalanított román–magyar közös történelem nem széles körű fogyasztásra alkalmas termék, de az MCC-történészkerekasztal előadói egyelőre optimisták.
„De hát én erdélyi vagyok, na” – a 90 éves Bodor Ádámot köszöntötték Kolozsváron
Varga László Edgár
Az író többek között arról beszélt, hogy ő „csak betévedt” az irodalomba, és arról is, milyen ambivalens érzésekkel tölti el a szülővárosába való visszatérés.